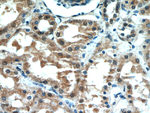
CBLL1 Antibody in Immunohistochemistry (Paraffin) (IHC (P))

Search
Proteintech
CBLL1 Polyclonal Antibody
{{$productOrderCtrl.translations['antibody.pdp.commerceCard.promotion.promotions']}}
{{$productOrderCtrl.translations['antibody.pdp.commerceCard.promotion.viewpromo']}}
{{$productOrderCtrl.translations['antibody.pdp.commerceCard.promotion.promocode']}}: {{promo.promoCode}} {{promo.promoTitle}} {{promo.promoDescription}}. {{$productOrderCtrl.translations['antibody.pdp.commerceCard.promotion.learnmore']}}
产品信息
21179-1-AP
种属反应
已发表种属
宿主/亚型
分类
类型
抗原
偶联物
形式
浓度
规格
纯化类型
保存液
内含物
保存条件
运输条件
产品详细信息
Immunogen sequence: TDNELQGTN SSGSLGGLDV RRRIPIKLIS KQANKAKPAP RTQRTINRMP AKAPPGDEEG FDYNEEERYD CKGGELFANQ RRFPGHLFWD FQINILGEKD DTPVHFCDKC GLPIKIYGRM IPCKHVFCYD CAILHEKKGD KMCPGCSDPV QRIEQCTRGS LFMCSIVQGC KRTYLSQRDL QAHINHRHMR AGKPVTRASL ENVHPPIAPP PTEIPERFIM PPDKHHMS (1-227 aa encoded by BC027460)
靶标信息
This gene encodes an E3 ubiquitin-ligase for the E-cadherin complex and mediates its ubiquitination, endocytosis, and degradation in the lysosomes. The encoded protein contains a RING-finger domain and is also thought to have a role in control of cell proliferation. A related pseudogene has been identified on chromosome X. Alternative splicing results in a non-coding transcript variant.
仅用于科研。不用于诊断过程。未经明确授权不得转售。
生物信息学
蛋白别名: c-Cbl-like protein 1; Cas-Br-M (murine) ecotropic retroviral transforming sequence-like 1; Casitas B-lineage lymphoma-transforming sequence-like protein 1; Cbl proto-oncogene like 1, E3 ubiquitin protein ligase; Cbl proto-oncogene, E3 ubiquitin protein ligase-like 1; E-cadherin binding protein E7; E3 ubiquitin-protein ligase Hakai; RING finger protein 188; RING-type E3 ubiquitin transferase Hakai; unnamed protein product
基因别名: AI467391; c-Cbl-like; CBLL1; HAKAI; RNF188
UniProt ID: (Human) Q75N03, (Mouse) Q9JIY2
Entrez Gene ID: (Human) 79872, (Mouse) 104836